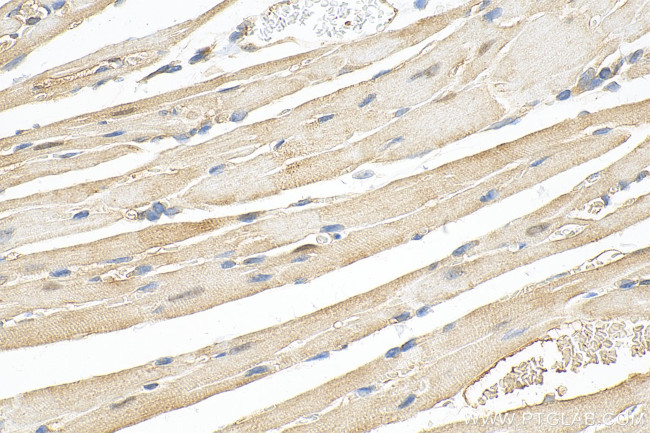
OLFML3 Antibody in Immunohistochemistry (Paraffin) (IHC (P))

Search
Proteintech
OLFML3 Polyclonal Antibody
{{$productOrderCtrl.translations['antibody.pdp.commerceCard.promotion.promotions']}}
{{$productOrderCtrl.translations['antibody.pdp.commerceCard.promotion.viewpromo']}}
{{$productOrderCtrl.translations['antibody.pdp.commerceCard.promotion.promocode']}}: {{promo.promoCode}} {{promo.promoTitle}} {{promo.promoDescription}}. {{$productOrderCtrl.translations['antibody.pdp.commerceCard.promotion.learnmore']}}
产品信息
15869-1-AP
种属反应
宿主/亚型
分类
类型
抗原
偶联物
形式
浓度
规格
纯化类型
保存液
内含物
保存条件
运输条件
产品详细信息
Immunogen sequence: RTEADTISGR VDRLEREVDY LETQNPALPC VEFDEKVTGG PGTKGKGRRN EKYDMVTDCG YTISQVRSMK ILKRFGGPAG LWTKDPLGQT EKIYVLDGTQ NDTAFVFPRL RDFTLAMAAR KASRVRVPFP WVGTGQLVYG GFLYFARRPP GRPGGGGEME NTLQLIKFHL ANRTVVDSSV FPAEGLIPPY GLTADTYIDL AADEEGLWAV YATREDDRHL CLAKLDPQTL DTEQQWDTPC PRENAEAAFV ICGTLYVVYN TRPASRARIQ CSFDASGTLT PERAALPYFP RRYGAHASLR YNPRERQLYA WDDGYQIVYK LEMRKKEEEV
靶标信息
This gene encodes a member of the olfactomedin-like gene family which also includes genes encoding noelin, tiarin, myocilin, amassin, optimedin, photomedin, and latrophilin. The encoded protein is a secreted extracellular matrix glycoprotein with a C-terminal olfactomedin domain that facilitates protein-protein interactions, cell adhesion, and intercellular interactions. It serves as both a scaffold protein that recruits bone morphogenetic protein 1 to its substrate chordin, and as a vascular tissue remodeler with pro-angiogenic properties. Alternative splicing results in multiple transcript variants. [provided by RefSeq, Feb 2017].
仅用于科研。不用于诊断过程。未经明确授权不得转售。
篇参考文献 (0)
生物信息学
蛋白别名: HNOEL-iso; hOLF44; olfactomedin, 44-kd; Olfactomedin-like protein 3; unnamed protein product
基因别名: 2810002E22Rik; AI115209; AW550633; HNOEL-iso; mONT3; OLF44; OLFML3; ONT3; PSEC0035; PSEC0173; PSEC0244; UNQ663/PRO1294
UniProt ID: (Human) Q9NRN5, (Mouse) Q8BK62
Entrez Gene ID: (Human) 56944, (Mouse) 99543